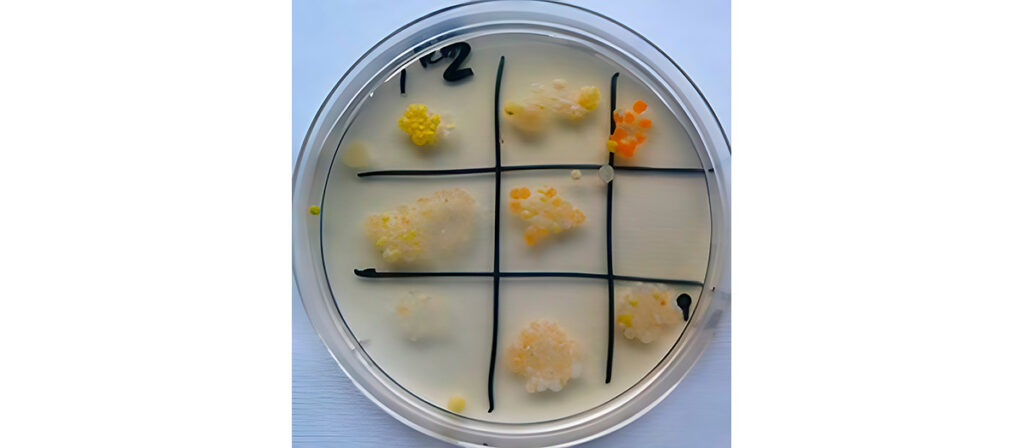

Reglamento General de Protección de Datos (RGPD)
De acuerdo con lo dispuesto en el artículo 13 del Reglamento UE 2016/679, del Parlamento Europeo y del Consejo, de 27 de abril, relativo a la protección de las personas físicas en lo que respecta al tratamiento de datos personales y a la libre circulación de estos datos, le informamos que sus datos pasan a formar parte de un fichero responsabilidad de la UPV/EHU, así como de los siguientes extremos:
| Información básica sobre Protección de Datos |
| Responsable del tratamiento de datos |
Universidad del País Vasco/ Euskal Herriko Unibertsitatea. |
| Finalidad del tratamiento de datos |
Gestión de la participación de las personas interesadas en los concursos y actividades organizados dentro de Zientzia Astea, la Semana de la Ciencia y la Tecnología de la Universidad del País Vasco/Euskal Herriko Unibertsitatea. Envío de información sobre próximas ediciones y actividades relacionadas con la divulgación científica. |
| Legitimación del tratamiento de datos |
Consentimiento de la persona interesada. La persona interesada tendrá derecho a retirar su consentimiento en cualquier momento, pero no afectará a la licitud del tratamiento basada en el consentimiento previamente otorgado. Asimismo, para el envío de información, el tratamiento se basa en el consentimiento de la persona interesada. |
| Destinatarios de cesiones de datos |
No se prevén cesiones de datos a terceros salvo previsión legal. |
| Derechos |
Acceder, rectificar y suprimir los datos, así como otros derechos, como se explica en la información adicional. |
| Información adicional |
Babestu |
Información adicional sobre protección de datos
Responsable
Responsable del tratamiento de sus datos:
- Identidad: Universidad del País Vasco/Euskal Herriko Unibertsitatea. CIF: Q4818001B.
- Dirección Postal: Barrio de Sarriena S/N 48940 Leioa (Bizkaia).
- Página web: www.ehu.eus
- Contacto del delegado de protección de datos: dpd@ehu.eus
Finalidad
¿Con qué finalidad tratamos sus datos personales?
La finalidad del tratamiento tiene por objeto gestionar la participación de las personas interesadas en los concursos y actividades que organiza anualmente la Universidad del País Vasco/Euskal Herriko Unibertsitatea en la Zientzia Astea, la Semana de la Ciencia y la Tecnología.
Por ello, la persona interesada está obligada a facilitar sus datos personales, ya que sin ellos no es posible la asistencia a las actividades de la Zientzia Astea.
Asimismo, tiene por finalidad el envío de información sobre determinados eventos y programas relacionados con EHUalumni, con su consentimiento, tanto por vía electrónica como postal.
Asimismo, tiene por finalidad el envío de información sobre próximas ediciones y actividades relacionadas con la divulgación científica, con su consentimiento, tanto por vía electrónica como postal.
¿Por cuánto tiempo conservaremos sus datos?
Los datos se conservarán mientras no se solicite su supresión por la persona interesada y, en cualquier caso, siempre que estén abiertos los plazos de recurso y/o reclamación procedente o mientras sigan respondiendo a la finalidad para la que fueron obtenidos.
Datos de carácter personal
¿Qué categorías de datos tratamos?
Las categorías de datos objeto de tratamiento son las siguientes:
- Datos de carácter identificativo: DNI/NIF, nombre y apellidos, dirección (postal, electrónica), teléfono, firma.
- Datos de características personales: lugar y fecha de nacimiento, sexo, edad, nacionalidad.
- Datos de circunstancias sociales: aficiones y estilos de vida.
Legitimación
¿Cuál es la legitimación para el tratamiento de sus datos?
La base legal para el tratamiento de sus datos es el consentimiento expreso de la persona interesada para los fines del tratamiento. La persona interesada tendrá derecho a retirar su consentimiento en cualquier momento, pero no afectará a la licitud del tratamiento basada en el consentimiento previamente otorgado.
Destinatarios
¿A qué destinatarios se comunicarán sus datos?
Los datos objetos del presente tratamiento no se cederán a terceros salvo previsión legal.
Derechos
¿Cuáles son sus derechos cuando nos facilita sus datos?
Cualquier persona tiene derecho a obtener confirmación sobre si en la UPV/EHU estamos tratando datos personales que les conciernan, o no.
Las personas interesadas tienen derecho a acceder a sus datos personales, así como a solicitar la rectificación de los datos inexactos o, en su caso, solicitar su supresión cuando, entre otros motivos, los datos ya no sean necesarios para los fines que fueron recogidos. La persona interesada tendrá también derecho a recibir los datos personales que le incumban en un formato estructurado, de uso común y lectura mecánica, y a transmitirlos a otro responsable del tratamiento, cuando el tratamiento se efectúe por medios automatizados.
En determinadas circunstancias, las personas interesadas podrán solicitar la limitación del tratamiento de sus datos, en cuyo caso únicamente los conservaremos para el ejercicio o la defensa de reclamaciones.
En determinadas circunstancias y por motivos relacionados con su situación particular, los interesados podrán oponerse al tratamiento de sus datos. La UPV/EHU dejará de tratar los datos, salvo por motivos legítimos imperiosos, o para el ejercicio o la defensa de posibles reclamaciones.
En particular, respecto del tratamiento de los datos con fines de envío de información, la UPV/EHU dejará de tratarlos con estas finalidades si la persona interesada se opone a dicho tratamiento.
Para el ejercicio de los derechos que le asisten dispone de formularios en el sitio web:
http://www.ehu.eus/babestu
Asimismo, dispone de información de la Agencia Vasca de Protección de Datos en el sitio web:
http://www.avpd.euskadi.eus